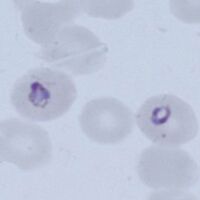

Gallery of early trophozoites: Difference between revisions
From haematologyetc.co.uk
No edit summary |
No edit summary |
||
| Line 25: | Line 25: | ||
---- | ---- | ||
<span style="font-size:95%">''' ''P.ovale'' '''</span></br> | <span style="font-size:95%">''' ''P.ovale'' '''</span></br> | ||
<span style="font-size:95%">As with the other species development begins with small forms and normal red cells; However as the species develops cahnges to red cells begin that might include finbriation, ovoid form and some enlargmnet. | <span style="font-size:95%">As with the other species development begins with small forms and normal red cells; However as the species develops cahnges to red cells begin that might include finbriation, ovoid form and some enlargmnet. Similar to ''P.vivax'' the cytoplasmic James (Schuffners) dots appear initially as a fine dots but becoming more prominent as the parasites mature. | ||
<gallery mode="traditional" widths=200px heights=200px> | <gallery mode="traditional" widths=200px heights=200px> | ||
| Line 35: | Line 35: | ||
---- | ---- | ||
<span style="font-size:95%">''' ''P.malariae'' '''</span></br> | <span style="font-size:95%">''' ''P.malariae'' '''</span></br> | ||
<span style="font-size:95%"> | <span style="font-size:95%">Generally parasites are infrequent. The very early small forms become a little more robust and may acquire features suggestive of the species that include a central chromatin dot, parasite elongation to form a band, or more solid and angular forms. Red cells have normal size and shape or may have reduced size, cytoplasmic dots should not be present. | ||
<gallery mode="traditional" widths=200px heights=200px> | <gallery mode="traditional" widths=200px heights=200px> | ||
Revision as of 12:49, 2 June 2024
Navigation
Go Back
P.falciparum
Small delicate rings, within red cells of normal (or slightly crenated) appearance.
These may be the only forms seen in some patients at diagnosis.
Some parasite forms are typical though not exclusive of the species, these include: accolé forms, double chromatin dot forms, and multiple parasites within infected red cells.
"
P.vivax
Rings begin as small forms in normal sized red cells, but as they develop both parasites and red cells become markedly enlarged and irregular. Schuffners dots develop during this stage initially as a fine dusting but becoming more prominent.
"
P.ovale
As with the other species development begins with small forms and normal red cells; However as the species develops cahnges to red cells begin that might include finbriation, ovoid form and some enlargmnet. Similar to P.vivax the cytoplasmic James (Schuffners) dots appear initially as a fine dots but becoming more prominent as the parasites mature.
"
P.malariae
Generally parasites are infrequent. The very early small forms become a little more robust and may acquire features suggestive of the species that include a central chromatin dot, parasite elongation to form a band, or more solid and angular forms. Red cells have normal size and shape or may have reduced size, cytoplasmic dots should not be present.

Ring with dots/fimbriation
"
P.knowlesi
As with the other species development begins with small forms and normal red cells; However as the species develops cahnges to red cells begin that might include finbriation, ovoid form and some enlargmnet. Liek in vivax the cytoplasmic James (Schuffners) dots appear initially as a fine dots but becoming more prominent as the parasites mature.
Ring early ovoid change
"

















